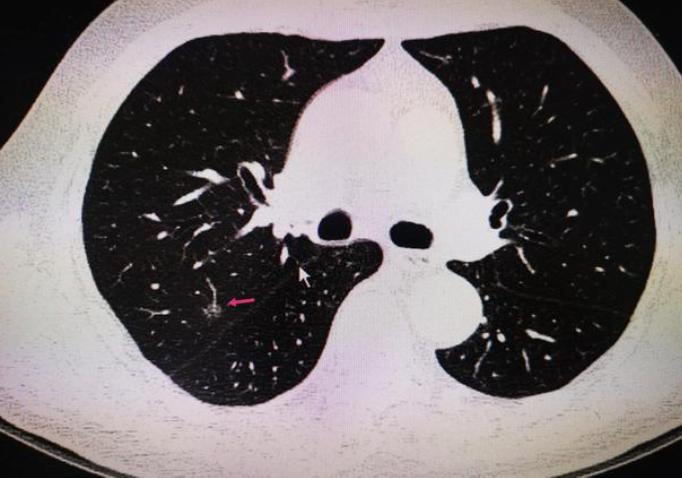
「门诊真实故事」咳嗽、胸闷、疲惫无力，这种肺结节我可以治

【门诊真实故事】咳嗽、胸闷、疲惫无力,这种肺结节我可以治!
记得四月份的时候有这样一个病人,卢某(化名),女,28岁,是一家公司的白领。

卢某最近一个月总是咳嗽、胸闷,刚出现症状的时候周某以为是感冒,所以没有在意。
但是随着咳嗽的症状越发严重,之前的胸闷没有好,现在觉得胸也跟着疼痛起来,每天觉得身体很累,没有力气,也吃不下什么食物。

卢某开始担心起来,在朋友的陪同下,到医院进行检查,经过检查,查出肺结节,报告如下:
“距脏层胸膜0.5cm处切面见结节1,直径0.7cm,切面灰白,质中,界清;距离支气管切缘5.1cm、距脏层胸膜0.4cm处切面见结节2,大小0.5*0.7*0.7cm。”
卢某说:“我们那里的医生建议我定期复查,随访观察肺结节的变化。钱主任你知道吗,听到这样的建议我很生气,我这人平时性子就比较急,我想尽快的治好我的肺结节。”
也是出于这个原因,卢某在朋友的陪同下来到了我这里。
是的,卢某的肺结节我可以治疗 。

【门诊真实故事】咳嗽、胸闷、疲惫无力,这种肺结节我可以治!
经过在给卢某把脉的时候我发现卢某的脉象沉细,又看了卢某的舌象,卢某的舌质偏红,有舌苔,舌苔薄白。
卢某的主要症状除了上面说的脾气比较急躁、食欲不振、胸闷、胸痛、疲乏无力、还有一点就是怕冷。

为什么我可以治疗肺结节?
虽然卢某的症状很复杂,但是好在病情不严重。通过上述的问诊情况结合脉诊与舌诊多考虑卢某的肺结节是由肝肾不足、肝郁气滞导致的。所以在治疗上可通过补益肾脏、疏肝解郁、行气化滞的手法进行治疗。
在用药的时候我选用了太子参、鸡内金、玄参、枳壳等药材用药,以此达到补益肾脏、疏肝解郁、行气化滞的目的。

振奋!患者传来的好消息,肺结节明显缩小了!
这个病人在我这里服药4周,胸闷、胸痛、疲惫无力的症状已经好转。我把方子微调了一下,然后告诉病人继续回去吃药,病人很是听话,回去又服用30剂药,上述说的两个结节已经全部消失了。
我很高兴我的医术能够帮到这个病人,看到这篇内容的你如果也有肺结节,或者其他方面的结节、肿瘤疾病可以随时咨询我或者留言给我,我一定会尽我所能帮到你。